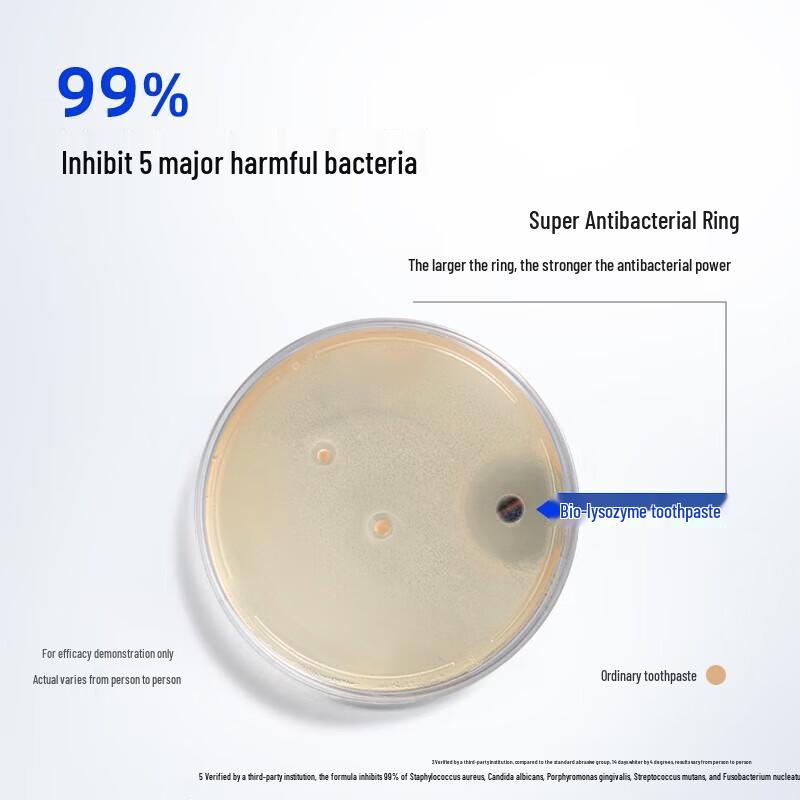
Namei Bio-Lysozyme Whitening Toothpaste 120g

Witryna nie obsługuje twojej przeglądarki. Zaktualizuj przeglądarkę lub pobierz inną
Namei Bio-Lysozyme Whitening Toothpaste 120g
Obecna cena
Cena 91,40 złz VAT

Model

Dostawa 5‑11 dni roboczych

Dostawa 13 zł
Warunki zwrotu
Bezpieczne płatności









Zespół wsparcia mówi po polsku
Bezpieczeństwo i zgodność z przepisami
Charakterystyki
Data ważności
3 lata
Opis
JDST online
4,5/259
Podobne artykuły